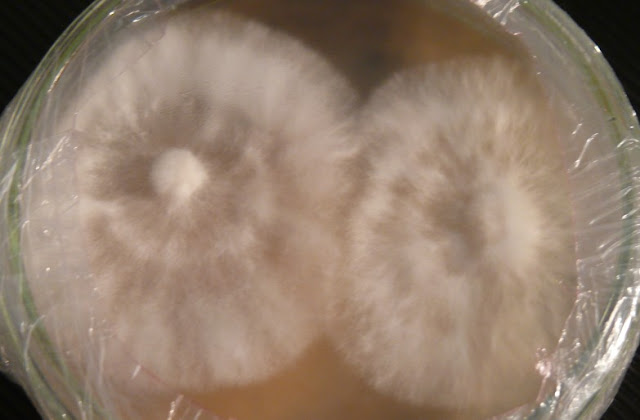

Text von Waldfrieden
Korrekturen und Ergänzungen von Mycelio, Pilz-Imperium
Hypholoma capnoides
Rauchblätriger Schwefelkopf
The Brown Gilled Clustered Woodlover
Allgemein:
Der deutsche Name Schwefelkopf klingt sicherlich nicht appetitanregend, wenn er nicht gar auf einen giftigen Pilz hindeutet, doch weit gefehlt: der Rauchblättrige Schwefelkopf ist ein sehr guter, schmackhafter Speisepilz und eigent sich auch sehr gut für die Pilzzucht.
Wer Ihn sammelt sollte sich aber vorsehen, denn er hat ein paar sehr ähnliche aussehende „Vewandte“ wie zum Beispiel der tödlich giftige Galerina marginata (Nadelholzhäubling), Hypholoma fasciculare (Grünblättriger Schwefelkopf) und dem ungenießbaren Hypholoma sublateritium (Ziegelroter Schwefelkopf).
Der Rauchblättrige Schwefelkopf hat ein sehr aggressiver Myzel und baut fast alle Nadelholzarten in Rekordzeit ab.
Standort:
Der Rauchblättrige Schwefelkopf ist das ganze Jahr über zu finden, vorwiegend aber doch im Spätsommer und Herbst. Er ist ein typischer Holzbewohner und wächst fast ausschließlich auf Fichten und Kiefern. Er kann gelegentlich auch auf dem Erdboden vorkommen, doch wird man, wenn man etwas gräbt, auf Totholz stossen, woher der Pilz seine Nährstoffe bezieht.
Er wurde bisher wild in Nordamerika und Europa gefunden. Dass er unter ähnlichen Klimatischen Bedinungen auch wächst ist nicht auszuschliessen, allerdings bis heute nicht bewiesen.
Aussehen:
Hut:
2-6 (-8) cm breit, gewölbt bis ausgebreitet, gelb bis braungelb mit dunkel
orangebraunem Scheitel, Rand mit vergänglichen hellen Velumresten.
Stiel:
4- 12 x 0,5- 1 cm, weißlich bis hellgelb, zur Basis rötlichbraun, ringlos,
schwach faserig, hohl.
Fleisch:
Blaßgelb bis cremeweiß, in der Stielbasis dunkler, oft rostbräunlich.
Geruch angenehm, Geschmack mild.
Lamellen:
cremeweißlich, im Alter rauchgrau bis grauviolett, mäßig gedrängt stehend,
angewachsen.
Sporenpulver:
braun, Sporengröße 6,5 - 8 (9) x 4-5 µm, elliptisch, mit deutlichem Keimporus.
Da die Stiele zäh sind, werden meist nur die Hüte verwendet.
Verwechslung:
H. capnoides (Rauchblättriger Schwefelkopf) kann mit anderen Hypholoma Arten, wie H. fasciculare (Grünblättriger Schwefelkopf) oder H. sublateritium (Ziegelroter Schwefelkopf) verwechselt werden.
Das beste Kennzeichen, um H. capnoides (Rauchblättriger Schwefelkopf) von H. fasciculare (Grünblättriger Schwefelkopf) zu unterscheiden, ist der grünliche Ton der Lamellen beim letzteren. Auch kann eine Geschmacksprobe durchgeführt werden. H. fasciculare (Grünblättriger Schwefelkopf) hat einen deutlich bitteren Geschmack. H. sublateritium (Ziegelroter Schwefelkopf) fällt durch seine deutliche rötliche Hutfärbung auf. Er ist ebenfalls bitter.
Anmerkung:
Im Spätherbst können Fruchtkörper auftreten die steril oder teilsteril sein können. In diesem Fall sind besonders die Lamellen bei H. capnoides fast cremeweißlich bis blass cremeocker. Die Fruchtkörper von H. fasciculare sind stets schwefelgelb bis grünlichgelb!
Heilwirkung:
Über die Heilwirkung des Rauchblättrigen Schwefelkopfes ist bis heute nichts genaueres Bekannt.
Schwierigkeitsgrad: leicht
Rauchblättriger Schwefelkopf - Hypholoma capnoides
Moderatoren: Mycelio, leuchtpilz, geriull
- Reblaus
- Ehren - Member
- Beiträge: 408
- Registriert: Mittwoch, 25. November 2009 22:02
- Wohnort: Wentorf bei Hamburg
- Kontaktdaten:
Re: Rauchblättriger Schwefelkopf - Hypholoma capnoides
Myzel auf MEYA nach ca. 3 Wochen bei ca. 20 °C